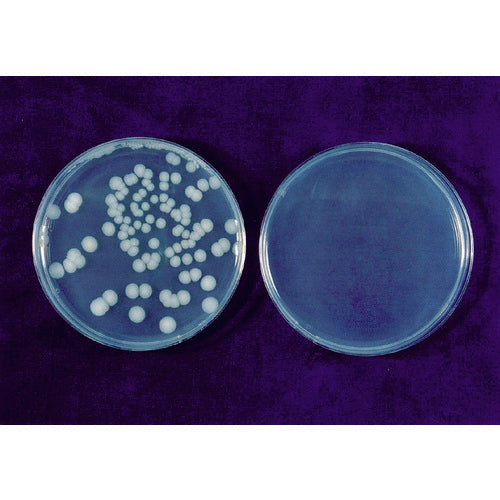

1
/
の
10
東京エレクトロン(株)
エレクトロン エアータオル KTM−100 KTM-100 1 台
エレクトロン エアータオル KTM−100 KTM-100 1 台
通常価格
¥71,148
通常価格
セール価格
¥71,148
単価
/
あたり
(税込み)
受取状況を読み込めませんでした
カタログ品番:KTM-100 特長:●ハイパワー温風(風速120m/s)でスピード乾燥ができます。●全て抗菌樹脂仕様で衛生的です。●上下分別設計ですので狭いスペースにも設置が可能です。●無電圧A接(自動扉連動仕様)です。(専用リード線が必要)●省エネ設計です。(最大730W-最小110W)●操作パネルロック機能で、電源ON/OFFの誤操作を防ぎます。●水受けカップの凹凸がないので、清掃しやすいです。 用途:●手指乾燥。 仕様:●色:ホワイト●電源(V):100●幅(mm):256●奥行(mm):148●消費電力(W):650●高さ(mm):490●タイプ:スタンダード●風速:120m/s●運転音:64dB●壁面取付型●オプション品で専用スタンド(床置)あり●スタンダードタイプ 注意:●コンクリート、タイル以外の壁面に取り付ける場合は、壁面の素材に合ったアンカーが必要です。
詳細を表示する